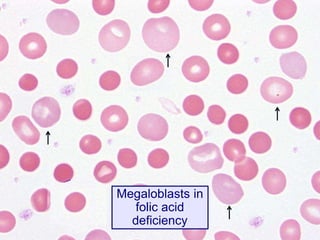
Megaloblasts in
folic acid
deficiency
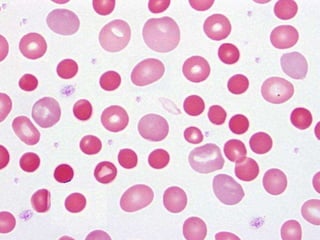

The document discusses water-soluble vitamins, which are essential organic compounds required in small amounts for normal health and growth. It highlights various water-soluble vitamins, including the B-complex family and vitamin C, their functions, deficiency diseases, and dietary sources. Specific focus is given to the chemical nature, significance, and clinical effects of thiamin (B1), riboflavin (B2), and niacin (B3), as well as the symptoms and treatment of related deficiencies.